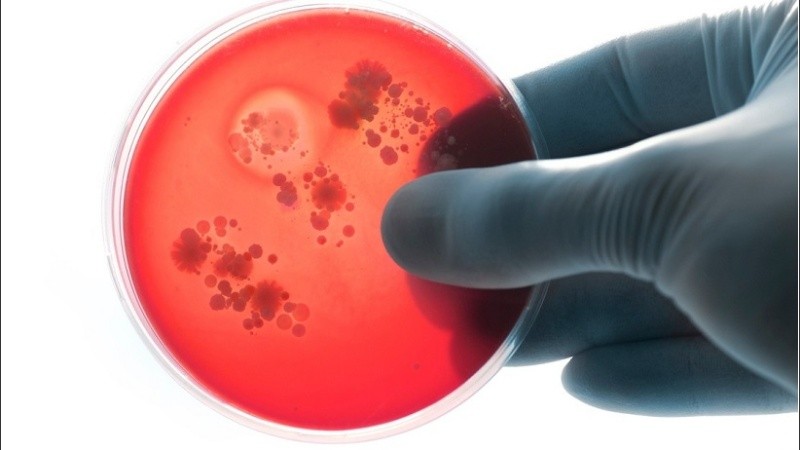

Los autores del estudio, publicado en la revista Environment International, analizaron muestras sanguíneas de 22 donantes anónimos, todos voluntarios en buena salud, y descubrieron microplásticos en 17 de entre ellos.
La mitad de las muestras contenía rastros de PET (politereftalato de etileno), uno de los plásticos más usados en el mundo, en particular en la fabricación de botellas y fibras de poliéster.,
Más de un tercio tenía poliestireno, usado entre otras cosas para el envasado de alimentos, y un cuarto polietileno.
"Por primera vez fuimos capaces de detectar y cuantificar" estos microplásticos en la sangre humana, declaró Dick Vethaak, ecotoxicólogo de la universidad libre de Ámsterdam.
"Esto prueba que tenemos plástico en nuestro cuerpo, y no deberíamos", dijo a la AFP.
Según el estudio, los microplásticos detectados pudieron penetrar en el cuerpo por múltiples vías: aéreas, acuáticas o por medio de la comida, o de los productos de higiene y cosmética.
"Es científicamente probable que partículas sanguíneas pueden ser llevadas hasta los órganos por medio del sistema sanguíneo", dijeron sus autores.
Este estudio fue financiando por la Organización Holandesa para la Investigación y el Desarrollo en Salud y por Common Seas, una ONG medioambiental con sede en Reino Unido que busca reducir la contaminación con plástico.
Para Alice Horton, especialista en contaminantes antrópicos del centro británico de oceanografía, "pese a la pequeña muestra y las débiles concentraciones detectadas", los métodos analíticos del estudio son "muy robustos".
"Este estudio contribuye a demostrar que las partículas de plástico no solo se encuentran presentes en el medioambiente, sino también en nuestros cuerpos. Las consecuencias a largo plazo aún no son bien conocidas", comentó al Science Media Centre.